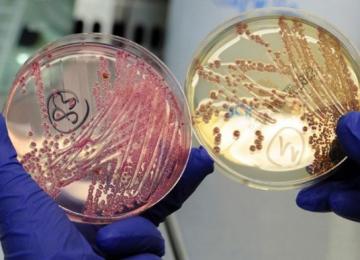

Strengthening social media literacy is the best strategy to counter social harm due to the pervasiveness of cyberspace. Over 30% of children and adolescents who fall victim to cyber harassment and…
People
Girls between 5 and 14 years old spend 40% more time, or 160 million more hours a day, on unpaid household chores and collecting water and firewood compared to boys their age, according to a…
The factors contributing to social harm have changed over the past years and the authorities need to shift focus and adopt new approaches to deal with the present-day challenges, said Minister of…
The Health Ministry is planning to change nursing methods currently taught in medical universities across the country, said Deputy Health Minister for Nursing Mohammad Mirzabeigi. “The current…
By the end of the current government’s tenure (in July 2017) 40 more hospitals will be constructed and equipped across the country, said a deputy minister for roads and urban development. “The…
Banners promoting Sustainable Development Goals (SDGs) have been displayed at Tehran Metro stations to raise awareness on the SDGs among the four million passengers who take the subway daily. The…
In the first six months of the current Iranian year (began March 20), more than 400,000 calls were made to the hotline for public complaints against the police, said the chief of Law Enforcement…
Drug-resistant infections have the potential to cause a level of economic damage similar to—and likely worse than—that caused by the 2008 financial crisis, according to a new report by the World…
Iranians consume an average 30% more calories than they actually need, said Dr Reza Malekzadeh, deputy of science and technology at the Health Ministry. “Excessive carbohydrates consumption (like…
The decline in the total fertility rate (TFR) in Iran can be attributed “to women’s higher education and employment,” according to Deputy Health Minister Ali Akbar Sayyari.
Only a few countries including Iran, Vietnam, Russia and Romania have managed to reduce maternal mortality rate (MMR) efficiently over the past few years, according to new data released recently…
More than three years ago the Chitgar artificial recreational lake in District 22 of Tehran Municipality was inaugurated. However, water supply to the lake has become a matter of concern.
The age of stroke or heart attack in Iran is 10 years below global average, according to Deputy Health Minister Reza Malekzadeh. “Among the 95,000 people who lose their lives to premature death…
Almost one third of all traffic accidents involve motorbikes, said Tehran Traffic Police Chief Brigadier General Teymour Hosseini on Thursday. “Around 33% of traffic accidents are caused by or…
Two special mobile buses for HIV/AIDS testing have been arranged by the Health Ministry in the underdeveloped and less privileged areas of Tehran to inform the residents about the disease. The…
Foreign investors looking to expand their operation to Iran are very particular about the environmental footprint of the tourism project they finance, unlike domestic entrepreneurs who are…
The unexpected announcement by Iran's top tourism chief last week that hotel prices will be deregulated has been received well by industry insiders who believe it will help spur growth and boost…
Tourism bodies in Scotland and Iceland are to formally work together to ensure both continue to “punch well above their weight on the global stage”.
Twenty-eight historical buildings in Shiraz, seven in Kerman, plus a number of others in Tehran, Qazvin and other cities are slated to be restored and reconstructed soon by Iran's Cultural…
German and Italian investors are following the footsteps of Chinese entrepreneurs by expressing eagerness to invest in Iran’s historical houses and caravansaries to reap their economic benefits.…
Tabiat (Nature) Pedestrian Bridge in Tehran has been named among the six winners of the 2016 Aga Khan Award for Architecture. The winners were announced on Monday in a ceremony in Abu Dhabi,…
Some 250 million children worldwide risk not reaching their full potential due to extreme poverty and stunting, cutting their future earnings by up to 26% and seriously impacting national growth,…
A total of 310 authorized food and drug testing laboratories are operating across the country under the auspices of the Food and Drug Administration. The laboratories will be connected to the…
For the first time in the country, air transportation of donor organs including heart, liver and kidney will be undertaken on the route from Bushehr to Tehran, said Mohammad Hadi Ayazi, social…
At the 63rd Session of the WHO Regional Committee for the Eastern Mediterranean Region on Wednesday, Health Minister Hassan Hashemi presented a report on the state of health in the region as well…